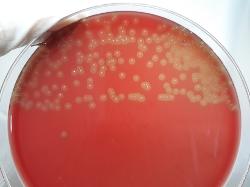

| Gemella haemolysans |
Taxonomy
Morphology
Cultural characteristics
Biochemical characters
Ecology
Pathogenicity
References
Phylum Bacillota (Firmicutes), Class Bacilli, Order Lactobacillales, Family Incertae sedis, Genus Gemella, Gemella haemolysans
(Thjotta & Boe 1938) Berger 1960, type species of the genus.
Old synonym: Neisseria haemolysans Thjotta and Boe 1938.
(Thjotta & Boe 1938) Berger 1960, type species of the genus.
Old synonym: Neisseria haemolysans Thjotta and Boe 1938.
Gram-positive cocci (sometimes Gram variable), 0.6 to 1.0 μm or more in diameter,
occurring singly, in pairs or in short chains, with adjacent sides flattened,,
nonsporing, nonmotile. Pleomorphism may be very pronounced, coccal forms are
frequently elongate, and cells may be of unequal size.
occurring singly, in pairs or in short chains, with adjacent sides flattened,,
nonsporing, nonmotile. Pleomorphism may be very pronounced, coccal forms are
frequently elongate, and cells may be of unequal size.
Colonies on blood agar plates after 2-3 days are smooth, nonchromogenic,
surrounded by a zone of clear beta-hemolysis by the second or third day (on rabbit
blood agar). Facultatively anaerobic, growth at 37 ºC, no growth at 10 or 45 ºC. No
growth in 6.5% NaCl broth. Bile esculin negative.
Grows on: Trypticase soy agar supplemented with blood, best on Mueller-Hinton agar
supplemented with rabbit blood. Growth is enhanced by CO2 enriched atmosphere.
surrounded by a zone of clear beta-hemolysis by the second or third day (on rabbit
blood agar). Facultatively anaerobic, growth at 37 ºC, no growth at 10 or 45 ºC. No
growth in 6.5% NaCl broth. Bile esculin negative.
Grows on: Trypticase soy agar supplemented with blood, best on Mueller-Hinton agar
supplemented with rabbit blood. Growth is enhanced by CO2 enriched atmosphere.
Isolated from blood cultures of patients with endocarditis and from CSF cultures of
patients with meningitis. Other sources: human bronchial secretions, nasopharynx,
dental plaque and swine intestinal content.
Isolated from chicken ocular secretion (admin note).
patients with meningitis. Other sources: human bronchial secretions, nasopharynx,
dental plaque and swine intestinal content.
Isolated from chicken ocular secretion (admin note).
Usually is an opportunistic pathogen from human and animal mucous membrane of
the respiratory tract. May cause conjunctivitis in chicken (admin note).
May cause various infections, particularly in immunocompromised patients.
the respiratory tract. May cause conjunctivitis in chicken (admin note).
May cause various infections, particularly in immunocompromised patients.
- Thjotta T. and Boe J.: Neisseria haemolysans. A hemolytic species of Neisseria Trevisan. Acta pathologica et Bacteriologica
Scandinavica Supplement, 1938, 37, 527-531. - Berger U.: Neisseria haemolysans (Thjøtta and Bøe 1938). Untersuchungen zur Stellung im System. Zeitschrift fur Hygiene und
Infektionskrankheiten Medizinische Mikrobiologie, Immunologie und Virologie, 1960, 146, 253-259. - Martin Dworkin, Stanley Falkow, Eugene Rosenberg, Karl-Heinz Schleifer, Erko Stackebrandt (Editors).: The Prokaryotes 3rd ed.: A
Handbook on the Biology of Bacteria Volume 4: Bacteria: Firmicutes, Cyanobacteria. 2006. - Matthew D. Collins And Enevold Falsen, 2009. Family XI. Incertae Sedis Genus I. Gemella Berger, 1960, 253AL. In: (Eds.) P.D.
Vos, G. Garrity, D. Jones, N.R. Krieg, W. Ludwig, F.A. Rainey, K.-H. Schleifer, W.B. Whitman. Bergey’s Manual of Systematic
Bacteriology, Volume 3: The Firmicutes, Springer, 455-460.
Positive results for alkaline phosphatase, acid production from glucose, fructose,
maltose and sucrose.
Negative results for esculin hydrolysis, gelatin hydrolysis, hippurate hydrolysis,
urease, casein degradation, coagulated serum liquefaction, indole production ,
beta-glucuronidase, alpha- and beta-galactosidase, acid production from
D-arabitol, L-arabinose, cyclodextrin, glycerol, melibiose, melezitose,
methyl-beta-D-glucopyranoside, pullulan, raffinose, ribose, trehalose, mannitol,
sorbitol, inulin or tagatose.
maltose and sucrose.
Negative results for esculin hydrolysis, gelatin hydrolysis, hippurate hydrolysis,
urease, casein degradation, coagulated serum liquefaction, indole production ,
beta-glucuronidase, alpha- and beta-galactosidase, acid production from
D-arabitol, L-arabinose, cyclodextrin, glycerol, melibiose, melezitose,
methyl-beta-D-glucopyranoside, pullulan, raffinose, ribose, trehalose, mannitol,
sorbitol, inulin or tagatose.

(c) Costin Stoica

| Antibiogram |
| Encyclopedia |
| Culture media |
| Biochemical tests |
| Stainings |
| Images |
| Movies |
| Articles |
| Identification |
| Software |
| R E G N U M PROKARYOTAE |
| Gemella haemolysans, beta-haemolytic colonies after 72h incubation on 5% sheep blood agar |
| Gemella haemolysans, Gram-stained cells |

| Back |